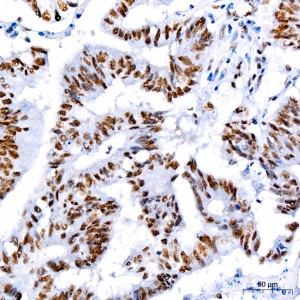
KO-Validated CDK9 Rabbit mAb (20 μl)

| Reactivity: | Human, Mouse, Rat |
| Applications: | WB, IHC, IF/IC, IP, ELISA |
| Host Species: | Rabbit |
| Isotype: | IgG |
| Clonality: | Monoclonal antibody |
| Gene Name: | cyclin dependent kinase 9 |
| Gene Symbol: | CDK9 |
| Synonyms: | TAK; C-2k; CTK1; CDC2L4; PITALRE; K9 |
| Gene ID: | 1025 |
| UniProt ID: | P50750 |
| Clone ID: | 1C4E3 |
| Immunogen: | A synthetic peptide corresponding to a sequence within amino acids 273-372 of human CDK9 (P50750). |
| Dilution: | WB 1:500-1:3000; IHC 1:200-1:2000; IF/IC 1:50-1:400 |
| Purification Method: | Affinity purification |
| Concentration: | 0.25 mg/mL |
| Buffer: | PBS with 0.02% sodium azide, 0.05% BSA, 50% glycerol, pH7.3. |
| Storage: | Store at -20°C. Avoid freeze / thaw cycles. |
| Documents: | Manual-CDK9 monoclonal antibody |
Background
The protein encoded by this gene is a member of the cyclin-dependent protein kinase (CDK) family. CDK family members are highly similar to the gene products of S. cerevisiae cdc28, and S. pombe cdc2, and known as important cell cycle regulators. This kinase was found to be a component of the multiprotein complex TAK/P-TEFb, which is an elongation factor for RNA polymerase II-directed transcription and functions by phosphorylating the C-terminal domain of the largest subunit of RNA polymerase II. This protein forms a complex with and is regulated by its regulatory subunit cyclin T or cyclin K. HIV-1 Tat protein was found to interact with this protein and cyclin T, which suggested a possible involvement of this protein in AIDS.
Images
 | Western blot analysis of various lysates using CDK9 Rabbit mAb (A11145) at 1:1000 dilution. Secondary antibody: HRP-conjugated Goat anti-Rabbit IgG (H+L) (AS014) at 1:10000 dilution. Lysates/proteins: 25μg per lane. Blocking buffer: 3% nonfat dry milk in TBST. Detection: ECL Basic Kit (RM00020). Exposure time: 3min. |
 | Western blot analysis of lysates from wild type(WT) and CDK9 knockout (KO) 293T cells, using [KO Validated] CDK9 Rabbit mAb (A11145) at 1:500 dilution. Secondary antibody: HRP-conjugated Goat anti-Rabbit IgG (H+L) (AS014) at 1:10000 dilution. Lysates/proteins: 25μg per lane. Blocking buffer: 3% nonfat dry milk in TBST. Detection: ECL Basic Kit (RM00020). Exposure time: 1s. |
 | Immunohistochemistry analysis of paraffin-embedded Human colon carcinoma tissue using [KO Validated] CDK9 Rabbit mAb (A11145) at dilution of 1:200 (40x lens). High pressure antigen retrieval performed with 0.01M Citrate Bufferr (pH 6.0) prior to IHC staining. |
 | Immunohistochemistry analysis of paraffin-embedded Human liver cancer tissue using [KO Validated] CDK9 Rabbit mAb (A11145) at dilution of 1:200 (40x lens). High pressure antigen retrieval performed with 0.01M Citrate Bufferr (pH 6.0) prior to IHC staining. |
 | Immunohistochemistry analysis of paraffin-embedded Mouse brain tissue using [KO Validated] CDK9 Rabbit mAb (A11145) at dilution of 1:200 (40x lens). High pressure antigen retrieval performed with 0.01M Citrate Bufferr (pH 6.0) prior to IHC staining. |
 | Immunohistochemistry analysis of paraffin-embedded Mouse colon tissue using [KO Validated] CDK9 Rabbit mAb (A11145) at dilution of 1:200 (40x lens). High pressure antigen retrieval performed with 0.01M Citrate Bufferr (pH 6.0) prior to IHC staining. |
 | Immunohistochemistry analysis of paraffin-embedded Mouse liver tissue using [KO Validated] CDK9 Rabbit mAb (A11145) at dilution of 1:200 (40x lens). High pressure antigen retrieval performed with 0.01M Citrate Bufferr (pH 6.0) prior to IHC staining. |
 | Immunohistochemistry analysis of paraffin-embedded Rat kidney tissue using [KO Validated] CDK9 Rabbit mAb (A11145) at dilution of 1:200 (40x lens). High pressure antigen retrieval performed with 0.01M Citrate Bufferr (pH 6.0) prior to IHC staining. |
You may also be interested in: